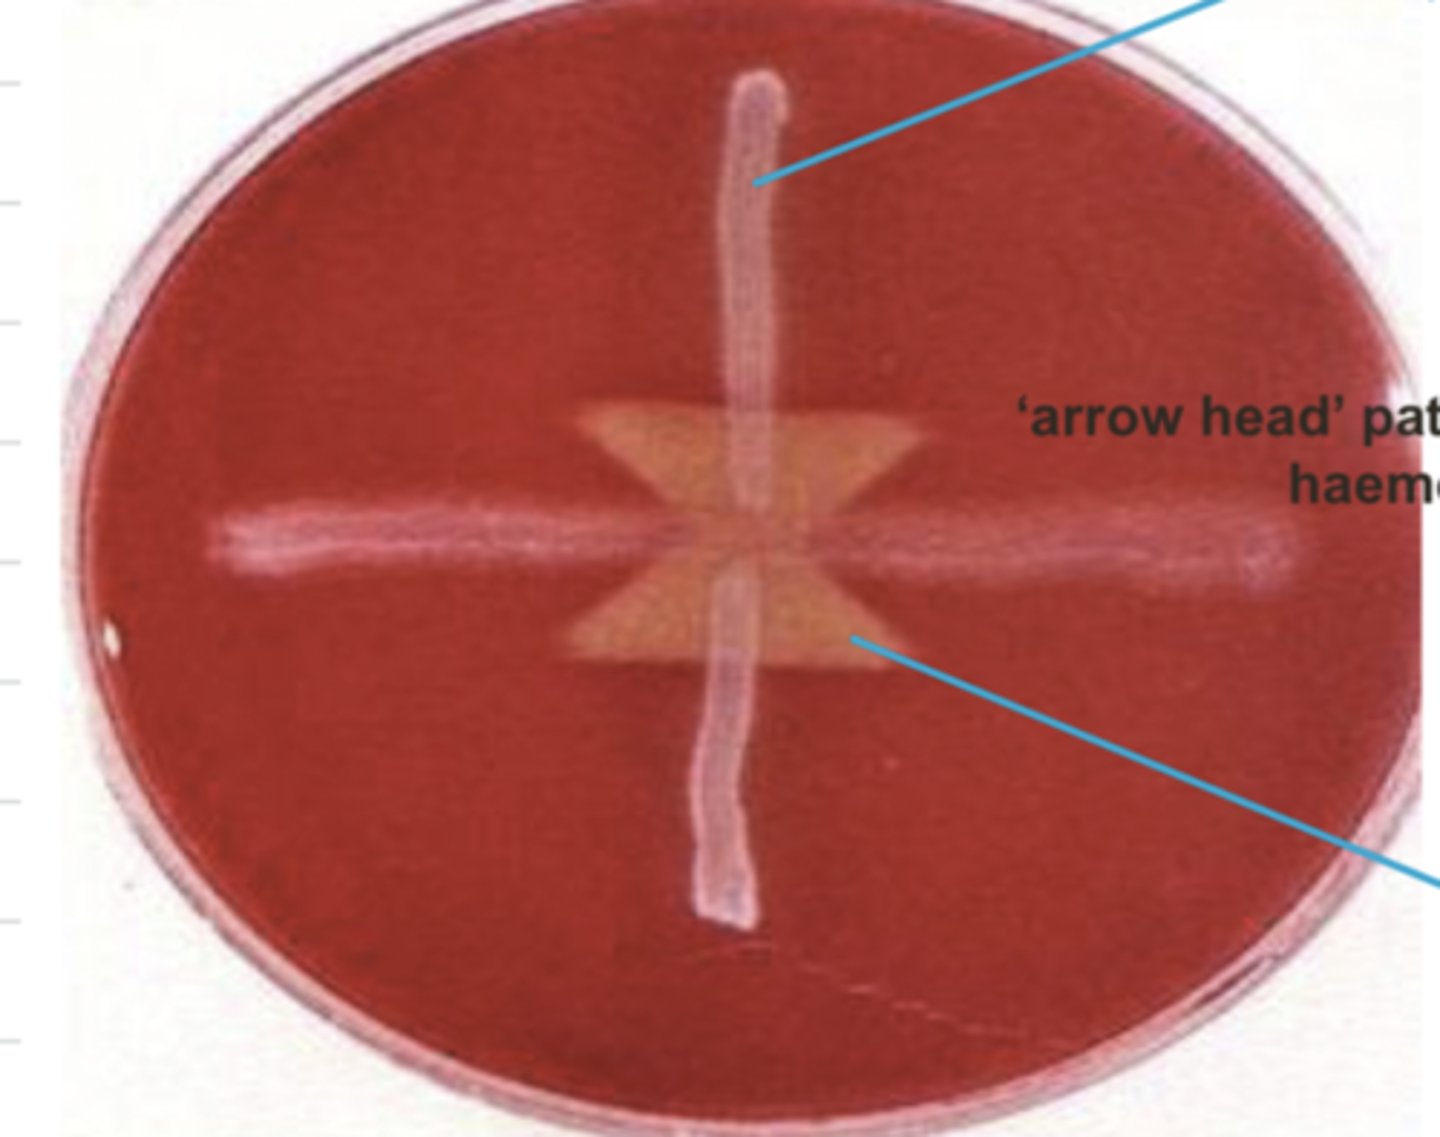
<p>what bacteria caused the arrowhead shape?</p>
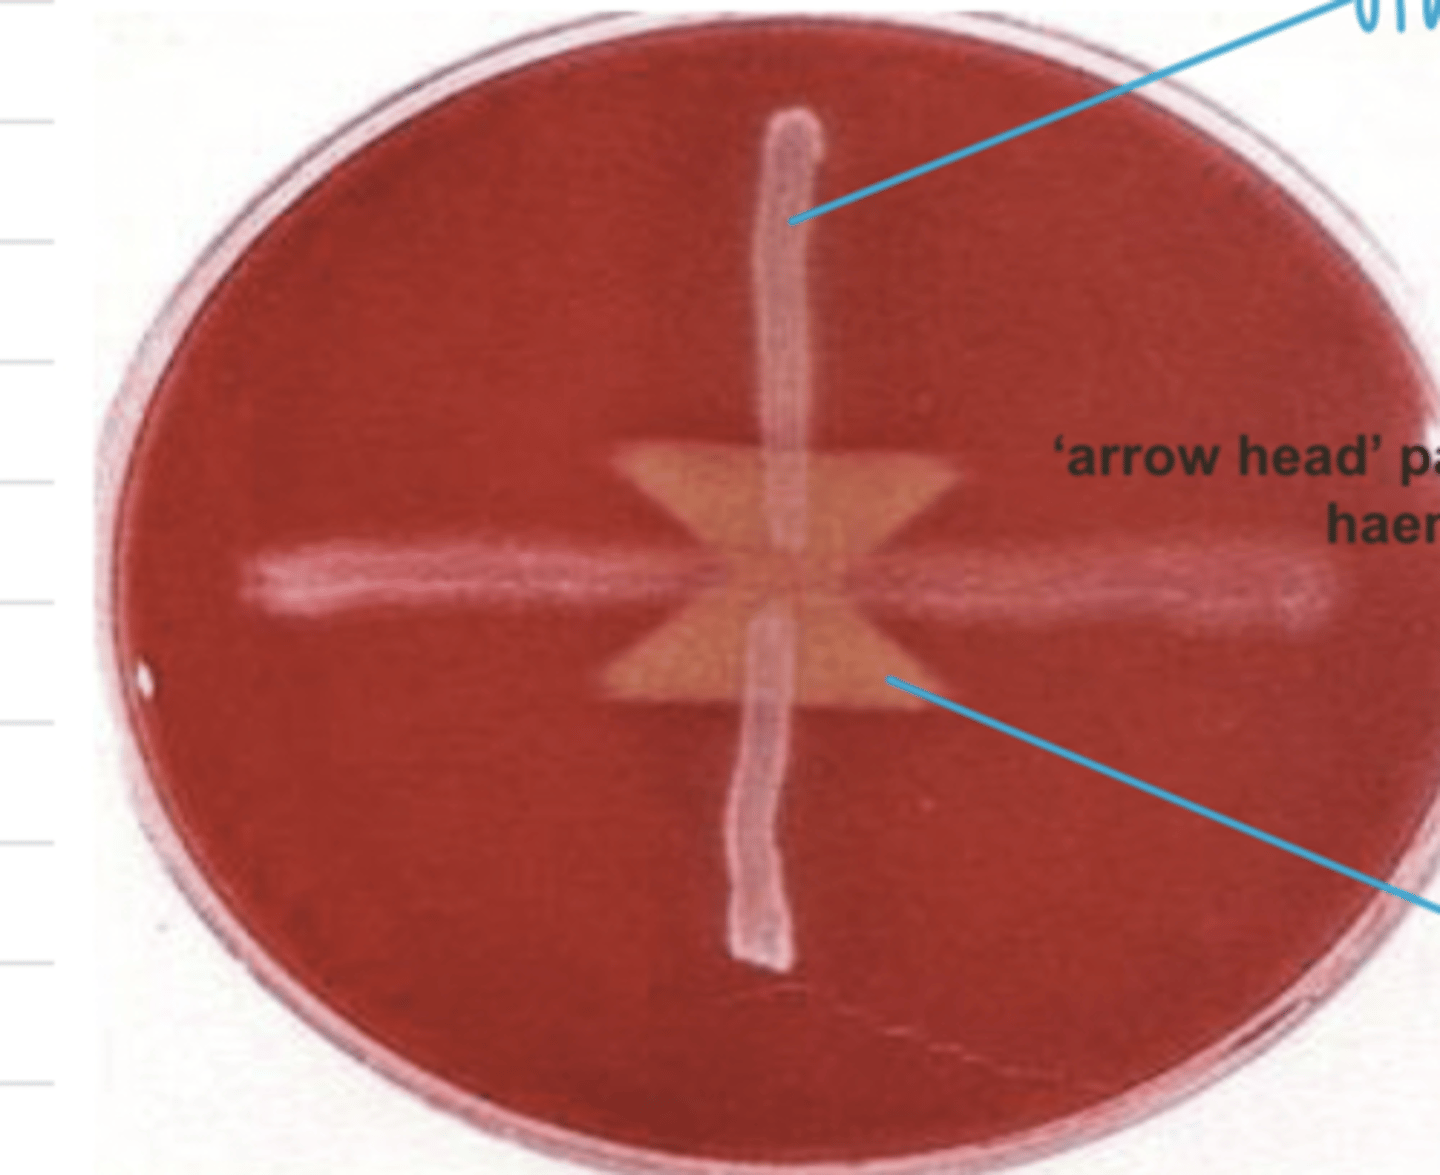
<p>which bacteria is used for the control/first hemolysis?</p>

1/91
Looks like no tags are added yet.
Name | Mastery | Learn | Test | Matching | Spaced | Call with Kai |
|---|
No analytics yet
Send a link to your students to track their progress
G+ (purple) cocci in clusters
how does Staphylococcus appear on a gram stain?
Staphylococcus
which, Staphylococcus or Streptococcus appears as cocci in clusters?
non-enriched media
where can Staphylococcus grow in the lab?
yes
can Staphylococcus grow on non enriched media?
catalase +
oxidase -
what are the results of the catalase and oxidase text of Staphylococcus?
yes
is Staphylococcus pyogenic?
in the environment or normally on mucous membranes in the upper respiratory tract, lower urogenital tract, and skin
where does Staphylococcus live?
both- it lives both in the environment and on the mucous membranes of animals
are infections of Staphylococcus endogenous or exogenous?
S. aureus
S. pseudointermedius
S. hyicus
what are the important Staphylococcus species?
Staphylococcus
which bacteria is this?

-traumas
-immunosuppression
-intercurrent infections
-allergic conditions
-endocrine and metabolic disturbances
what factors predispose an animal to an Staphylococcus infection?
mastitis in cattle
Staphylococcus aureus causes _______ in what animals?
pigs, sheep, goats, horses, dogs, cats, poultry
Staphylococcus aureus mainly infects _______, but can also cause skin problems in what species?
dogs and cats
what species can be infected by Staphylococcus pseudointermedius?
skin problems, otitis, cystitis, endometritis
what problems does Staphylococcus pseudointermedius cause in dogs and cats?
Staphylococcus pseudointermedius
which species causes skin problems, otitis, cystitis, and endometritis in dogs and cats?
S. hyicus
which species of Staphylococcus mainly infects pigs?
Staphylococcus hyicus
which species causes exudative epidermitis in pigs?
Greasy Pig Disease
what disease does Staphylococcus hyicus cause?
Staphylococcus hyicus
which bacteria causes Greasy Pig Disease?
Staphylococcus aureus
which species caused this?

S. aureus
which species of Staphylococcus commonly causes mastitis in cattle?

used for infections of Staphylococcus aureus to diagnose subclinical mastitis.
to perform it, we mix milk from each teat with the reagent, and if there are clots- there is mastitis
what is the california test used for?

california test
what test is used to diagnose subclinical mastitis?
Staphylococcus aureus (but these symptoms are also caused by S. pseudointermedius)
skin scrapings, or swab if there are secretions
this dermatitis was caused by the species ______. what specimens would we take?

Greasy Pig Disease (exudative epidermitis)
caused by Staphylococcus hyicus
what is this disease? it is caused by which bacteria?

Staphylococcus pseudointermedialis
this otitis was caused by what species of bacteria?

-antiphagocytic proteins in the cell wall
-exotoxins: enterotoxins, toxic shock syndrome toxins, exfoliative toxins
what are the virulence factors of Staphylococcus?
exfoliative toxins
which toxins do Staphylococcus produce that cause skin lesions?
coagulase, catalase
what enzymes do Staphylococcus produce?
transforms fibrinogen to fibrin, which protects the bacteria
what does the enzyme coagulase do?
allows survival inside of phagocytes because it inhibits free radical actions
what does the enzyme catalase do?
Staphylococcus
what bacteria is this?

any affect- it can be alpha, beta, or gamma
on blood agar, what is the effect of Staphylococcus?
yes- facultatively (with or without O2), at 37 degrees
can Staphylococcus grow on non enriched media?
gamma- no hemolysis
what type of hemolysis does Staphylococcus hyicus produce on blood agar?
negative, positive
Staphylococcus is oxidase _________ and catalase ________
S. agalactiae
S. dysgalactiae
S. equi
S. zooepidermicus
S. suis
S. canis
what are the important species of Streptococcus?
beta
what type of hemolysis does Streptococcus agalactiae produce on blood agar?
alpha
what type of hemolysis does Streptococcus dysgalactiae produce on blood agar?
beta
what type of hemolysis does Streptococcus equi produce on blood agar?
beta
what type of hemolysis does Streptococcus zooepidermicus produce on blood agar?
alpha
what type of hemolysis does Streptococcus suis produce on blood agar?
beta
what type of hemolysis does Streptococcus canis produce on blood agar?
cattle, sheep, goats, humans, dogs
what species does Streptococcus agalactiae affect?
cattle and lambs
what species are infected by Streptococcus dysgalactiae?
Streptococcus equi
what species of Streptococcus only infects horses?
horses, cattle, lambs, pigs, poultry
what species does Streptococcus zooepidermicus infect?
pigs and humans
what species does Streptococcus suis infect?
carnivores
Streptococcus canis infect what species?
S. agalactiae, S. dysgalactiae
which species of Streptococcus causes mastitis in cattle?
milk ducts and vagina of cattle, sheep, goats, humans, and dogs
what is the usual habitat of Streptococcus agalactiae?
neonatal septicemia
what affect does Streptococcus agalactiae have on dogs and humans?
chronic mastitis
what affect does an infection of Streptococcus agalactiae have on cattle, sheep, and goats?
buccal cavity and vagina of cattle and lambs and the environment
what is the usual habitat of Streptococcus dysgalactiae?
cattle- acute mastitis
lambs- polyarthritis
what is the effect of Streptococcus dysgalactiae on cattle and lambs?
Streptococcus dysgalactiae
what bacteria causes polyarthritis in lambs?
strangles
what is the effect of Streptococcus equi on horses?
Streptococcus equi
which bacteria causes strangles in horses?
upper resp. tract and guttural pouch of horses
what is the normal habitat of Streptococcus equi?
Streptococcus equi
which bacteria normally lives in the guttural pouches and URT of horses?
mastitis, pneumonia, navel infections
what is the effect of Streptococcus zooepidermicus on horses?
mucous membranes of horses
skin and mucous membranes of cattle, lambs, pigs, and poultry
what is the natural habitat of Streptococcus zooepidermicus?
suppurative conditions, septicemia
if cattle, lamb, pigs, or poultry have a Streptococcus zooepidermicus infection, what are the signs?
Streptococcus suis
which bacteria normally lives in the tonsils or nasal cavity of pigs and humans?
the tonsils or nasal cavity of pigs and humans
Streptococcus suis normally lives in_____
septicemia, meningitis (Porcine Streptococcal Meningitis), arthritis, bronchopneumonia
Streptococcus suis causes what conditions in pigs?
meningitis, septicemia
what effects does a Streptococcus suis infection have on humans?
vagina and anal mucosa of carnivores
where does Streptococcus canis usually live?
neonatal septicemia, suppurative conditions, toxic shock syndrome
Streptococcus canis has what type of effect in carnivores?
Streptococcus canis
which Streptococcus species normally lives in the anal mucosa or vagina of carnivores?
G+ (purple) cocci in chains
how does Streptococcus appear when using the gram stain?
Streptococcus
which bacteria?

Streptococcus
which bacteria?

Streptococcus
which Staphylococcus or Streptococcus is more sensitive to environmental conditions, so becomes pathogenic more easily?
abscesses, septicemia, and suppurative lesions
what are the main causes of Streptococcus?
Streptococcus suis
what bacteria causes Porcine Streptococcal Meningitis?

Streptococcus agalactiae OR Streptococcus dysgalactiae
what species of Streptococcus caused this?

Streptococcus equi
what bacteria causes strangles?

Streptococcus suis, pneumonia, arthritis, meningitis
Porcine Streptococcus Meningitis is caused by __________ and causes what problems?

Streptococcus suis
what bacteria caused this?

Streptococcus equi
fever, nasal discharge, abscesation of lymph nodes
what are the symptoms of strangles? what bacteria causes it?
Streptococcus
which bacteria is highly susceptible to dessication?
Streptococcus
what bacteria?

no
can Streptococcus grow on non enriched media?
negative, negative
Streptococcus is catalase_________ and oxidase _________
Streptococcus
which, Streptococcus or Staphylococcus, is CAMP positive?
arrowhead
Streptococcus forms what shape in the CAMP test?
Streptococcus
what bacteria caused the arrowhead shape?
Staphylococcus aureus
which bacteria is used for the control/first hemolysis?
a serological method of classifying Streptococcus species based on the antigen
what is the lancefield classification?
Staphylococcus
which, Staphylococcus or Streptococcus caused these lesions?
